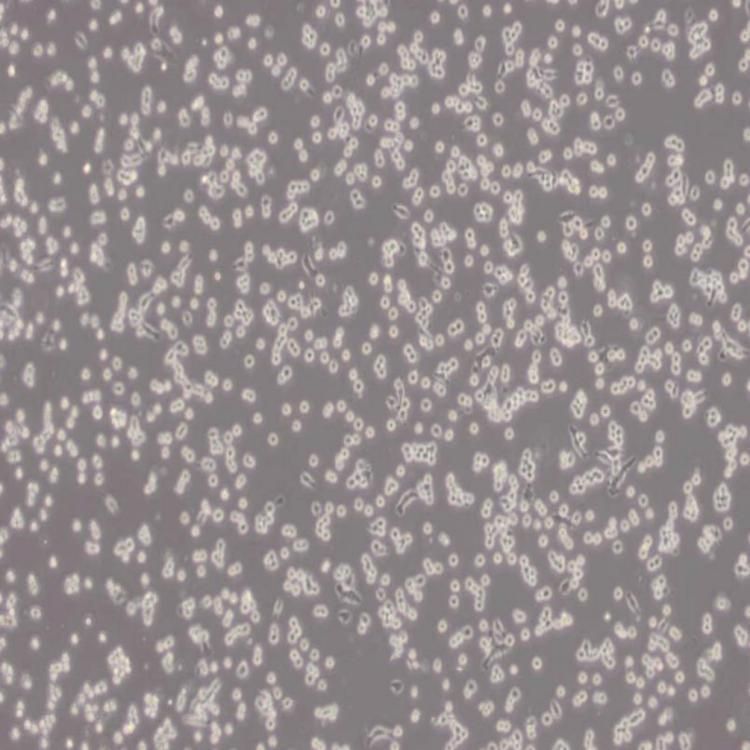
35.1杂交瘤细胞抗CD2

万千商家帮你免费找货
0 人在求购买到急需产品
- 详细信息
- 文献和实验
- 技术资料
- 库存:
999
- 供应商:
江西江蓝纯生物试剂有限公司
- 英文名:
35.1杂交瘤细胞抗CD2
- 规格:
T25培养瓶
35.1_(杂交瘤细胞抗CD2)背景描述:动物用佛波醇肉豆寇酸(PMA)活化的人T淋巴细胞免疫。 脾细胞与gp2/O-Agl4骨髓瘤细胞融合。 抗体与人T细胞表面蛋白Tp50(CD2)反应。 抗体抑制T细胞增殖反应和细胞毒反应,但不抑制抗体倡导的细胞毒反应。
种 属:小鼠
生长特性:悬浮细胞
细胞形态:淋巴母细胞样
生长培养基:RPMI-1640+10% FBS+1% P/S
推荐传代比例:3×10^5-5×10^5cells/mL
推荐换液频率:2~3次/周
冻存条件:
冻存液:55% 基础培养基+40%FBS+5%DMSO
温 度:液氮
35.1_(杂交瘤细胞抗CD2)培养条件:
气 相:空气,95%;CO2,5%
注意事项:该细胞为悬浮细胞,请注意离心收集细胞悬液;请勿直接倒掉细胞培养液。
江蓝纯--试剂品牌由上海机纯实业有限公司和江西江蓝纯生物试剂有限公司联合打造的一个科研品牌,生产和销售高纯度特种化学品和生命科学研发用试剂产品,领域涵盖化学、分析化学、生命科学和材料科学等基础创新领域的产品,主要有精细化学试剂,电泳试剂、色谱试剂、离心分离试剂、免疫试剂、标记试剂、组织化学试剂、培养基、缓冲剂、电镜试剂、蛋白质和核酸沉淀剂、缩合剂、超滤膜、染色剂、抗氧化剂、去垢剂和表面活性剂、生化标准品试剂、生化质控品试剂、分离材料等等。
风险提示:丁香通仅作为第三方平台,为商家信息发布提供平台空间。用户咨询产品时请注意保护个人信息及财产安全,合理判断,谨慎选购商品,商家和用户对交易行为负责。对于医疗器械类产品,请先查证核实企业经营资质和医疗器械产品注册证情况。
文献和实验―杂交瘤技术、DNA重组技术等。 单抗的制备首先将抗原注射人小鼠体内,然后从小鼠脾脏中获得能够产生抗体的B细胞,与小鼠骨髓瘤细胞在灭活的仙台病毒或聚乙二醇的诱导下融合,再在特定的选择性培养基中筛选出杂交瘤细胞。由于杂交瘤细胞继承了双亲细胞的遗传物质,因此,它不仅具有B细胞分泌特异性抗体的能力,还有骨髓瘤细胞在体外培养条件下大量增殖的本领。由此可以获得足够数量的细胞。 单抗的制备过程 1,抗细胞表面分子的单抗 这类抗体能识别和结合表达特定膜表面分子的细胞
的分子,如CD2、CD4、CD8、CD28、CD31、CD50、CD54、CD56、CD58、CD80、CD102、CD106等。 (5)有CD命名的CR有CR1(CD35)、CR2(CD21)、CR3(CD11b\CD18)、CR4(CD11c/CD18)和C5aR(CD88),其中CR3和CR4属于粘附分子中整合素超家族成员。 (6)有CD编号的CKR有CD115~CDw130;属于IGSF结构的CKR有CD115、CD
1975年Kohler和Milstein发现将小鼠骨髓瘤细胞与和绵羊红细胞免疫的小鼠脾细胞进行融合,形成的杂交瘤细胞既可产生抗体,又可无性繁殖,从而创立了单克隆抗体杂交瘤技术。这一技术上的突破使血清学的研究进入了一个高度精确的新纪元。 免疫细胞化学的 技术关键之一是制备特异性强、亲合力大、滴度高的特异性抗体,由于每种抗原都有几个抗原决定簇,用它免疫动物将产生对各个决定簇的抗体,即多克隆抗体。单克隆抗体则是由一个产生抗体的细胞与一个骨髓瘤细胞融合而形成的杂交廇细胞经无性繁殖而来